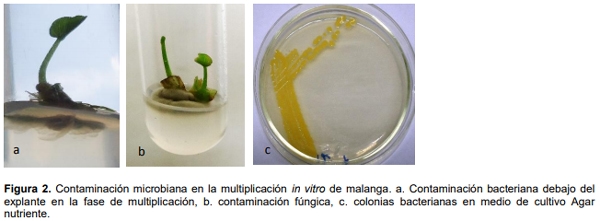
Influencia de la edad fisiológica de la planta donante sobre contaminantes microbianos en la micropropagacion de Colocasia Esculenta (l.) Schott - Image 2

INTRODUCCIÓN
La malanga (Colocasia esculenta (L.) Schott), es una de los rizomas tropicales de mayor demanda y tiene gran importancia socioeconómica. En los países tropicales y subtropicales la malanga es un producto valioso que es utilizado como fuente de energía, carbohidratos y proteínas contribuyendo a la seguridad alimentaria. El cormo es la parte principal que se comercializa y en muchos países en desarrollo es un cultivo que constituye una fuente importante de ingresos para pequeños productores de zonas rurales y marginales, además es una alternativa para zonas donde existen suelos anegados los cuales no son aptos para la mayoría de cultivos (Viloria y Córdova, 2008).
La disponibilidad de material vegetal de siembra se ve limitada por carencia de semilla de calidad y por la incidencia de patógenos (Espinosa et al., 2012). Las técnicas biotecnológicas han permitido proveer a los productores un material vegetal rejuvenecido y saneado, con alto potencial productivo. La propagación in vitro de este cultivo ha sido informada por varios autores (García et al., 1999; Rodríguez et al., 2003; Goswami et al. 2012; Gálvez et al. 2013).
Para iniciar los trabajos de cultivo in vitro, en primera instancia, dicha selección está dada por el objetivo perseguido, se emplean plantas sanas y vigorosas, y dentro de éstas, las zonas que se encuentran en activa división, como los meristemos. Las plantas jóvenes aportan los explantes más reactivos, ya que la totipotencialidad disminuye con la edad, los explantes jóvenes no leñosos, en estado vegetativo y de mayor tamaño, tienen mayor capacidad de regeneración y adaptación in vitro (Pierik, 1990).
Uno de los principales problemas que afecta las plantas propagadas mediante la técnica de cultivo de tejidos, tanto en laboratorios comerciales como en investigación, es la contaminación microbiana. En los laboratorios causan pérdidas del 3 al 15% en cada subcultivo lo que ha impulsado diversas investigaciones para encontrar formas para evitar este problema (Leifert et al. 1994a). Esta contaminación se traduce en bacterias y hongos, los cuales son comunes en las plantas in vivo, sin embargo son nocivas para las plantas in vitro (Skirvin et al. 1999).
Existen varios factores en la propagación masiva de plantas que pueden influir directa o indirectamente sobre las contaminaciones microbianas. La edad y el estado fisiológico de la planta donante es uno de los factores que influye en su capacidad morfogénica (Styer y Chin, 1983), mientras más joven y menos diferenciado esté el tejido mejor será la respuesta in vitro (Villalobos, 1982).
Por lo antes referido la presente investigación tiene como objetivos determinar la influencia de la edad fisiológica de la planta donante sobre contaminaciones microbianas en la micropropagación de la malanga, así como aislar y caracterizar morfológica y culturalmente los principales contaminantes.
MATERIALES Y MÉTODOS
Material Vegetal
El trabajo se realizó en el Instituto de Investigaciones de Viandas Tropicales (INIVIT). Se emplearon plantas in vitro de malanga (C. esculenta) de los cultivares (cv.) ‘INIVIT MC-2001’, ‘INIVIT MC-2005’ e ‘INIVIT MC-2012’, provenientes del Banco de Germoplasma del INIVIT (García et al., 1999; Gálvez et al., 2013) en fases de establecimiento y multiplicación, establecidas a partir de meristemos y yemas axilares de plantas donantes de diferentes edades fisiológicas (tres, seis y nueve meses) para determinar la influencia sobre la incidencia de contaminantes microbianos.
Determinación de la influencia de los contaminantes microbianos según la edad fisiológica de la planta donante
Para determinar la incidencia de contaminantes microbianos, cada 72 horas se procedió a la revisión del material vegetal por observación visual desde el establecimiento hasta el tercer subcultivo de multiplicación (subcultivos cada 21 días) en cada cultivar. Se cuantificaron los recipientes de cultivo (tubos de ensayo) donde se observó la presencia de crecimiento microbiano. Se comparó la incidencia de contaminantes microbianos entre los tratamientos, se calculó el porcentaje de contaminación en cada subcultivo y se determinó cuál de los cultivares con edades fisiológicas diferentes presentaron menor afectación por contaminantes microbianos.
Aislamiento de bacterias
Los grupos microbianos presentes en los tubos contaminados se identificaron a través de observaciones microscópicas directas (aumento 400x). De los recipientes de cultivo donde se comprobó la presencia de bacterias se realizaron aislamientos por agotamiento por estrías en placas de Petri con medio de cultivo Agar Nutriente (BIOCEN) (AN). Las placas se incubaron durante 24-72 horas a 30°C. Se obtuvieron cultivos puros por resiembra en el mismo medio de cultivo. De los aislados con caracteres culturales diferentes (por observación en microscopio estereoscópico), se describieron caracteres morfológicos (forma y agrupación) (400x y 1000x) en preparaciones microscópicas directas y teñidas (tinción simple y tinción de Gram).
RESULTADOS Y DISCUSIÓN
Durante la propagación in vitro de los tres cultivares estudiados (‘INIVIT MC-2001’, ‘INIVIT MC2005’ e ‘INIVIT MC-2012’) con diferentes edades fisiológicas (tres, seis y nueve meses) se constató la presencia de hongos filamentosos y bacterias en la fase de establecimiento tanto para meristemos como para yemas axilares (Figura 1 A y B). Estos ocasionaron cambios de coloración del medio de cultivo, opacidad o turbidez. En la fase de establecimiento se observó turbidez en el medio de cultivo líquido, con aspecto viscoso y en la fase de multiplicación el crecimiento microbiano se presentó principalmente dentro del medio de cultivo en la zona debajo de la base del explante (Figura 2). La fase de establecimiento in vitro constituye la etapa fundamental en la micropropagación de la malanga, pues de la forma en que se maneje ésta, depende la disminución de contaminantes microbianos

En la fase de multiplicación predominaron los contaminantes bacterianos, causando porcentajes de pérdidas a los nueve meses de 24,12% en ‘INIVIT MC-2001’; 8,12% en ‘INIVIT MC-2005’ (meristemos), 14,44% en ‘INIVIT MC-2001’, 12,19% en ‘INIVIT MC-2005’ (yemas) y a los tres meses para meristemos 18,15% y 10,32% para yemas en el cultivar ‘INIVIT MC-2012’, en los subcultivos de la fase de multiplicación. Con el aumento del número de subcultivos los porcentajes de contaminación también se incrementaron, excepto en el tercer subcultivo del cultivar ‘INIVIT MC-2012’ procedente yemas axilares y meristemos (Figura 3A y B). Estos resultados indicaron que la contaminación microbiana en estos materiales vegetales puede proceder del explante inicial. Gutiérrez et al. (2015) obtuvieron resultados similares en las fases de establecimiento y multiplicación in vitro del cultivar de malanga ‘INIVIT MC-2012’ donde se comprobó una alta incidencia de contaminantes microbianos, con predominio de bacterias que causaron afectaciones al material vegetal. Otros autores como Hernández et al. (2005) y Folgueras (2006) han referido también que las bacterias causan mayor incidencia con respecto a otros microorganismos contaminantes en otros cultivares de malanga.

Existen numerosos microorganismos asociados a los tejidos de las plantas, que pueden aparecer como contaminantes cuando estas son cultivadas in vitro y se conoce que con el incremento del número de subcultivos la presencia de contaminantes bacterianos puede ser mayor (Cassells y Leifert, 2001; Alvarado-Capó et al., 2003).
Para la propagación in vitro de los cultivares estudiados no se le realizaron las pruebas para la detección temprana de contaminantes microbianos (Santos et al., 2005), por lo que no pudieron ser detectados mediante la observación visual. Se observaron frascos de cultivos contaminados durante la micropropagación de la malanga con edades fisiológicas diferentes, donde los microrganismos afectaron el crecimiento del material vegetal y en otros casos no causaba daños. Resultados similares fueron obtenidos por los autores Thomas y Prakash (2004) y Gutierrez et al. (2015) en los cultivares de malanga ‘INIVIT MC-2012’ e ‘INIVIT MX-2007’ donde observaron bacterias asociadas al explante inicial, creciendo sobre o en el medio de cultivo.
Se obtuvieron 10 aislados bacterianos de cada cultivar con diferentes edades fisiológicas y fase de la propagación in vitro con caracteres culturales diferentes y morfología de cocos o bacilos. Predominaron las bacterias Gram (+) y la morfología bacilar (Tabla 1). En investigaciones anteriores Carrazana et al. (2011) informaron de la presencia de bacterias de tipo bacilar, G+, esporógenas, bacilos G- y cocos G+ en el cultivo in vitro de X. sagittifolium L. Schot cv. México 08, el primero dependiente del tejido vegetal para crecer en el medio de cultivo y los últimos de origen ambiental. No fue posible establecer el origen de cada uno de los aislados en los cultivares estudiados, aunque posiblemente la mayoría se asocia al explante, por la ubicación en el medio de cultivo siempre debajo de la base de este.

Aunque el cultivo in vitro de la malanga ha sido abordado por varios autores (Rodríguez et al., 2003; Carrazana et al., 2011; Goswami et al., 2012; Gálvez et al., 2013; Santos et al., 2015 y Gutierrez et al., 2015) no se encontraron referencias en la literatura consultada sobre datos de la influencia de la edad fisiológica de la planta donante sobre contaminantes microbianos.
Se determinó que la edad fisiológica de la planta donante influyó sobre contaminantes microbianos durante la propagación in vitro de la malanga. Para los cultivares ‘INIVIT MC-2001’ e ‘INIVIT MC-2005’ la menor incidencia de contaminantes microbianos fue a los seis meses y a los nueve meses para ‘INIVIT MC-2012’ mostrándose de igual forma los explantes procedentes de meristemos y yemas axilares (Figura 4). En investigaciones realizadas en el cultivo in vitro de Xanthosoma sagittifolium L. Schott, autores como Vilchez et al. 2011 trabajaron con plantas donantes de 2 meses de edad, obteniendo como resultado el 30% de afectación por contaminación microbiana.
Tanto el estado fisiológico como sanitario de la planta que da el explante (planta donante) influyen significativamente en su capacidad morfogénica. Se ha encontrado, por ejemplo, que los requerimientos nutricionales y hormonales difieren cuando los tejidos provienen de plantas en diferentes edades fisiológicas. El éxito en el cultivo in vitro está en parte influenciado por factores inherentes al explante, incluido el tamaño, la edad fisiológica, la fuente del órgano o tejido y el genotipo (Weldt, 2008).

La contaminación por microorganismos es la causa más importante de pérdidas en laboratorios comerciales y de investigación de cultivo de células y tejidos vegetales (Alvarado-Capó et al., 2003). Entre los principales problemas para el establecimiento in vitro de la malanga, está la contaminación causada por bacterias, debido a que las plantas madres generalmente vienen infectadas desde el campo con estos patógenos, lo cual dificulta la introducción in vitro de este cultivo. Por ello, entre las estrategias de control de la contaminación microbiana se han adoptado medidas tales como tratamiento a las plantas donantes, inclusión de antibióticos en el medio de cultivo (Barret y Cassells, 1994) o la aplicación en varias fases de la propagación de métodos de detección temprana de contaminantes (indexing) (Santos et al., 2005; Carrazana et al., 2011). Los resultados de este trabajo corroboran la necesidad de una estrategia integral que permita disminuir la incidencia de contaminantes asociados al explante inicial del cultivo in vitro de la malanga. La edad fisiológica de la planta donante sin duda es uno de los principales factores a tener en cuenta a la hora de seleccionar el material vegetal para el establecimiento in vitro por la disminución de microorganismos contaminantes, sin descartar aquellos que pueden ser introducidos en el proceso por inadecuadas técnicas de asepsia y manipulación del material vegetal.
Poseer información sobre los principales microorganismos contaminantes del cultivo de la malanga y la edad fisiológica óptima de la planta donante (en el establecimiento in vitro) constituye una valiosa herramienta de trabajo que posibilitará proveer a los productores una semilla de calidad, con alto potencial productivo.
CONCLUSIONES
- Durante la propagación in vitro de los cultivares de malanga ‘INIVIT MC-2001’, ‘INIVIT MC2005’ e ‘INIVIT MC-2012’ se comprobó una alta incidencia de contaminantes microbianos, con predominio de bacterias que causaron afectaciones al material vegetal.
- Se obtuvieron aislados bacterianos con caracteres culturales diferentes y morfología de cocos o bacilos, predominando las bacterias Gram (+), siendo estas las que causaron mayores afectaciones en las fases de establecimiento y multiplicación.
- Se determinó que a los seis meses los cultivares ‘INIVIT MC-2001’ e ‘INIVIT MC-2005’ tuvieron menor incidencia de contaminantes microbianos y el cultivar ‘INIVIT MC-2012’ a los nueve meses mostrándose de igual forma los explantes procedentes de meristemos y yemas axilares.
BIBLIOGRAFÍA
Barrett C, Cassells A (1994) An evaluation of antibiotics for the elimination of Xanthomonas campestris pv. Pelagonii (Brown) from Pelargonium x domesticum cv. Grand Slam explants in vitro. Plant Cell, Tissue and Organ Culture 36: 169-175.
Cabrera, D., J. González., O. Portal y R. Hernández (2010) Influencia del virus del mosaico de la malanga sobre el contenido de clorofilas en Xanthosoma nigrum (VELL.) Genotipo INIVIT M 95- 1 (en línea). Consultado el 12 de enero de 2016. Disponible en: http://scielo.sld.cu/scielo.php?pid=S1010-27522010000300008&script=sci_arttext.
Carrazana D, Santos A, Alderete Y, Gálvez D, Cupull R, Navarro M (2011) Bacteria endófita latente no vitropatógena en el cultivo in vitro de Xanthosoma sagittifolium (L. Schot). Centro Agrícola 38(4): 21-29.
Espinosa E, Herrera L, Dávila A, Espinosa A, Figueroa Y, Armario D, Pérez D, Aguiar J, Chamizo M (2012) Efecto del material vegetal de plantación sobre la incidencia de pudriciones secas en Colocasia esculenta (L.) Schott y Xanthosoma spp. Biotecnología Vegetal 12 (4): 235-244.
Folgueras M (2006) La contaminación microbiana en la micropropagación in vitro de las raíces y tubérculos tropicales. Centro agrícola 33(2): 91.
Gálvez D, Cabrera M, Beovides Y, Robaina A, Rodríguez S, Rodríguez D (2013) Establecimiento in vitro de yemas axilares del cultivar de Colocasia esculenta Schott ‘INIVIT MC-2001’. Biotecnología Vegetal 13 (2): 107-112.
García M, Mederos V, Rodríguez S, López J, Ventura J, Cabrera M, Hernández R, Gonzáles JE, Bermúdez D, Gálvez D, Gutiérrez V, Gálvez JR (1999) Generalización de la metodología para la micropropagación de la malanga (Xanthosoma spp.) en Cuba. 5to Coloquio Internacional de Biotecnología Vegetal, pp. 167-169. IBP. Santa Clara.
Goswami A, Singh B, Gaurav S, Singh A, Kumar At (2012) Tissue culturing of taro (Colocasia esculenta (L.) Schsott) in in –vitro conditions. Progressive Agriculture 12 (1): 158-163.
Gutierrez Y, Torres Y, Robaina A, Bauta M, Rayas A, A Santos, Basail M, López J, Mederos V, Beovides, Rodríguez D (2015) Incidencia de contaminantes microbianos en la propagación in vitro de Xathosoma spp. clon ‘INIVIT MX-2007’ y Colocasia esculenta (L.) Schott. clon ‘INIVIT MC-2012’ Biotecnología Vegetal 15 (3): 157-161.
Hernández R, Lugo Y, González J, González Y, Rojas X, Herrera L (2005) Detección de microorganismos contaminantes del cultivo in vitro de la malanga.
Leifert C, Morris CE, Waites WM (1994) Ecology of microbial saprophytes and pathogens in tissue culture and field grown plants: reason for contamination problems in vitro. Critical Reviews in Plant Sciences 13: 139-183.
Pierik R, (1990) Cultivo in vitro de las plantas superiores. Ediciones Mundi- Prensa, España. pp: 15-18, 49-52, 67-80, 109-120.
Rodríguez A, Quintero S, Rodríguez A, Fundora Z (2003) Establecimiento in vitro de apices de malanga (Xanthosoma sagittifolium Schoott). Cultivos Tropicales 24(3): 19-22.
Santos A, García M, Carrazana D, López J, Ventura J, Basail M, Medero V, Cabrera M, Rayas A, Gálvez D, Bauta M, Álvarez M, Ortega A (2005) Prevención de la contaminación microbiana en la micropropagación de la malanga clon ‘Camerún 14’ (Colocasia esculenta). Centro Agrícola 32(3): 31-34.
Santos A, Reinaldo D, López, M Basail, Medero V, Gutiérrez Y, Rayas A, Beovides Y, Bauta M (2015) Incremento de la eficiencia en el establecimiento in vitro de la malanga ‘INIVIT MC-2012’ (Colocasia esculenta (l.) Schott.) Rev. Agricultura Tropical 1 (1): 70-74.
Skirvin R, Motoike S, Norton M, Ozgur M, Al-Juboory K, McMeans O, (1999) Workshop on micropropagation, establishment of contaminant-free perennial plants in vitro. In Vitro Cell. Dev Biol.-Plant. 35: 296-298.
Styer D, y Chin C (1983) Meristem and shoot-tip culture for propagation, pathogen elimination, and germplasm conservation. Horticultural Reviews. 5: 221-227.
Thomas P, Prakash GS (2004) Sanitizing long-term micropropagated grapes from covert and endophytic bacteria and preliminary field testing of plants after 8 years in vitro. In Vitro Cell. Dev. Biol.-Plant 40: 603-607.
Vilchez J, Albany N, Martínez L, Molina M, Alvarez C, Leal E, Bermúdez L (2011) Establecimiento in vitro de ocumo blanco (Xanthosoma sagittifolium (L.) Schott) Rev. Fac. Agron. 28 (1): 434- 444.
Villalobos A (1982) Tissue culture applied to ornamental species. En: Micropropagation of selected root crop, ornamental species. Rome, J. (eds). pp: 155-164.
Viloria H y Córdova C (2008) Sistema de producción de ocumo chino (Colocasia esculenta (L.)Schott) en la parroquia Manuel Renaud del municipio de Antonio Díaz del estado Delta Amacuro, Venezuela. Revista UDO agrícola 8 (1): 98-106.
Weldt, E (2008) Establecimiento, multiplicación y enraizamiento in vitro de Rosa canina L. Tesis en opción al grado de Licenciado en Agronomía. Universidad Austral de Chile. Valdivia-Chile.